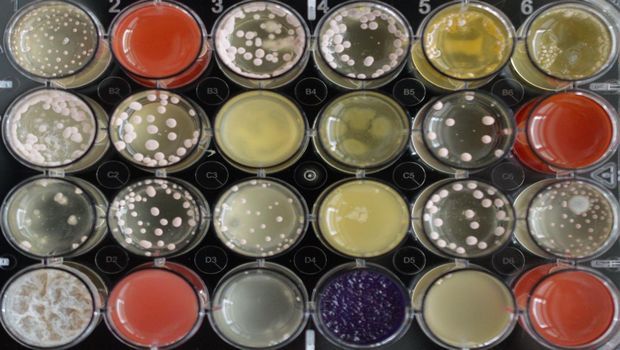

Besides mushrooms such as truffles or morels, also many yeast and mold fungi, as well as other filamentous fungi belong to the Ascomycota phylum. They produce metabolic products which can act as natural antibiotics to combat bacteria and other pathogens. Penicillin, one of the oldest antibiotic agents, is probably the best known example. Since then, fungi have been regarded as a promising biological source of antibiotic compounds. Researchers expect that there is also remedy for resistant pathogens among these metabolites.

Fungi can be cultivated in the laboratory and stimulated with distinct substances for production of antibiotic metabolic products. Courtesy of BiMM Research/Bioactive Microbial Metabolites
Besides mushrooms such as truffles or morels, also many yeast and mold fungi, as well as other filamentous fungi belong to the Ascomycota phylum. They produce metabolic products which can act as natural antibiotics to combat bacteria and other pathogens. Penicillin, one of the oldest antibiotic agents, is probably the best known example. Since then, fungi have been regarded as a promising biological source of antibiotic compounds. Researchers expect that there is also remedy for resistant pathogens among these metabolites.
However, agents like penicillin are only produced when necessary, not permanently. "Fungi can even deactivate the respective parts of their genome if a metabolite is not needed anymore. These compounds can't be detected any longer and are classified as cryptic compounds," explained Christoph Zutz from the Institute for Milk Hygiene, Milk Technology and Food Science of the Vetmeduni Vienna.
The right stimulus can re-induce the production of antibiotic compounds. The researchers used valproic acid which can induce the activation of such deactivated genes in fungi. In the fungus Doratomyces microsporus, valproic acid even induced the production of several antimicrobial compounds.
The gained metabolites were effective against a "normal" as well as resistant Staphylococcus aureus pathogens. The team succeeded in filtering out the six most active compounds from all metabolites. These six compounds have been regarded as "cryptic" so far. One compound, cyclo-(L-proline-L-methionine) or cPM, could be detected even for the first time in a fungus. The only source of this compound so far has been a bacterium living in an Antarctic sponge.
The as yet "cryptic" compound cPM has a special function. It boosts the activity of other antimicrobial compounds. The team assumes that particularly this boosting effect constitutes the effect these compounds have on the tested pathogens.
Therefore, the researchers went a step further and tested the newly detected compound cPM together with ampicillin in two ampicillin-resistant bacteria. The combination has proved successful. "The resistance was demonstrably reduced, even at a lower dose of ampicillin than usually," said co-author and corresponding group leader Kathrin Rychli.
The team is now going to search for novel antibiotic compounds from other microorganisms by applying similar methods. The new research platform "Bioactive Microbial Metabolites" (BiMM) in Tulln provides the facility. BiMM represents the detection of bioactive compounds - metabolites - in microorganisms. "Valproic acid is not the only way to gain active compounds from fungi or other microorganisms. You can also make bacteria and fungi grow together. This also leads to a natural stimulus," explained Joseph Strauss from the University of Natural Resources and Life Sciences, Vienna, who heads the platform. For this purpose, researchers from the University of Veterinary Medicine, Vienna and the University of Natural Resources and Life Sciences, Vienna founded this new research core facility.
Zutz identified a significant advantage of this inter-university research platform: "Unlike industrial enterprises, we investigate all promising metabolites in microorganisms, not only single chemical compounds. Thus, we consider known and cryptic compounds in our analyses."
Source: University of Veterinary Medicine, Vienna
Stay prepared and protected with Infection Control Today's newsletter, delivering essential updates, best practices, and expert insights for infection preventionists.